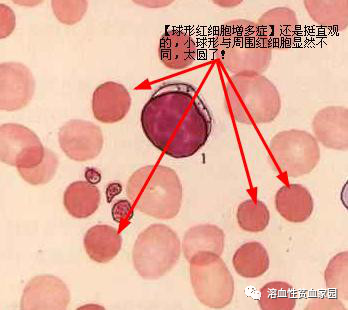
认识疾病｜溶血性贫血之遗传性球形红细胞增多症（HS）

一个小宝宝呱呱坠地,但没几天小宝宝的面色就变得苍黄,在医生坚持不懈地努力下,终于查出来孩子到底是得了什么病——遗传性球形红细胞增多症(HS)。
原来这是一种遗传性疾病,孩子的父亲就患有这种病,几年前还做了脾切除术,除了父亲之外几个大伯、姑姑也有面色苍黄的情况,可惜家里人并不懂如何避免遗传性疾病,导致小宝宝刚生下就面临劫难。今天咱们就来聊一聊遗传性球形红细胞增多症(HS)。

图源:摄图网
正常人的红细胞是双凹圆盘状,细胞的膜上有许多蛋白,它们相互盘绕,像钢筋弹簧一样维持着红细胞的盘状形态,这样红细胞表面面积较大、变形能力也强,当血液流经脾脏时,红细胞就可以通过变形的方式穿越比它直径小得多的脾微循环结构。
但遗传性球形红细胞增多症(HS)患者基因异常,产生的红细胞是球形的,因此细胞表面积减少,变形能力减弱,而脆性随之增加,穿越脾脏毛细血管时就变得很困难,容易被脾脏破坏。红细胞破坏增多,便导致溶血性贫血。
 图源:济南市儿童医院公众号
图源:济南市儿童医院公众号
溶血后红细胞中裂解出的大量血红蛋白会分解生成“胆红素”,引起皮肤、巩膜黄染,这种临床表现叫做“黄疸”。脾脏也由于红细胞在此破坏、刺激增生而越来越大,然后继发脾大。
这种疾病如何治疗?相信看了上面的内容,大家能够猜到根本的治疗方法就是切脾,脾脏是破坏红细胞的器官,切除脾脏溶血自然会恢复。除此之外只能进行对症治疗,输血或药物治疗,叶酸、重组人促红素注射液等。
这种方式可有效阻止严重地贫患儿的出生,但可能需要反复人工流产或中晚期终止妊娠,需要面临终止妊娠带来的并发症如宫腔粘连及其造成的妊娠困难等。
第三代试管婴儿技术又称为胚胎植入前遗传学诊断,可以诊断胚胎是否由携带致病基因,筛选出健康的胚胎进行移植,降低严重遗传病患儿的出生风险,降低出生缺陷率。
 图源:摄图网
图源:摄图网
遗传性球形红细胞增多症是一种遗传性疾病,因此做好产前检查是避免发生悲剧的重中之重,希望能够引起重视。
参考文献:
[1]覃玉妹,廖林,邓雪连等.SPTB基因新型复合杂合突变致遗传性球形红细胞增多症遗传学分析及产前诊断[J].中国实验血液学杂志,2022,30(02):552-558.DOI:10.19746/j.cnki.issn1009-2137.2022.02.039.
声明丨本文中涉及的内容信息仅用作疾病知识参考和学习,如需获得治疗方案指导,请前往正规医院就诊!

图源:济南市儿童医院公众号
图源:济南市儿童医院公众号 图源:摄图网
图源:摄图网





